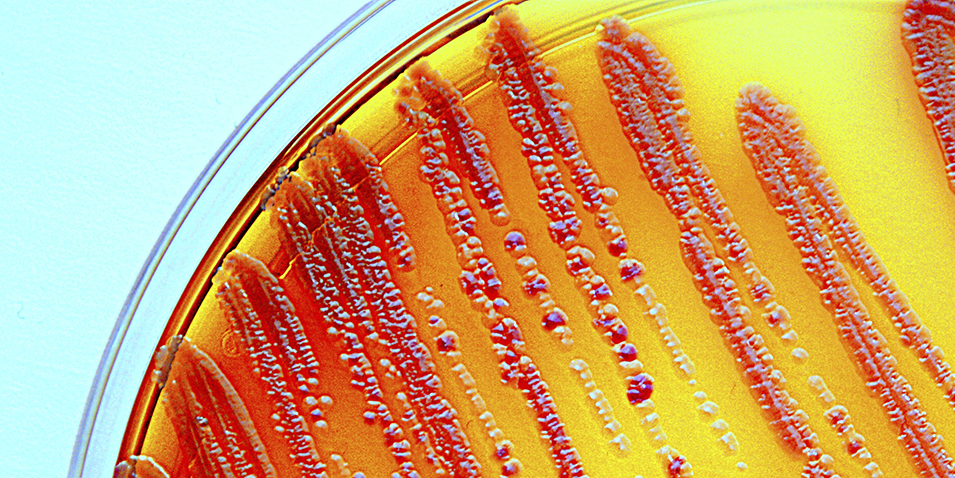

Delade substansbibliotek kan ge effektivare läkemedelsutveckling
Högkvalitativa substansbibliotek är utgångspunkten för framgångsrik läkemedelsutveckling. I fjol slöt AstraZeneca och Sanofi ett unikt avtal om att öppna sina bibliotek och dela 210 000 kemiska föreningar med varandra.
- Forskning
- Onsdag 24 februari 2016
EU-rapport: Bättre samordning behövs för utveckling av antibiotika

Edith Schippers, minister för sjukvård, välfärd och idrott i Nederländerna, var värd för EU-ministermötet den 10 februari då rapporten presenterades.Det finns ett överflöd av initiativ inom forskning och utveckling av nya antibiotika för att möta de växande medicinska hoten från resistens hos de mikroorganismer man vill bekämpa med antimikrobiella läkemedel. I en ny rapport till det nederländska ordförandeskapet för EU:s ministerråd under första halvåret 2016 ges förslag till samordning för att undvika dubbelarbete och göra mer tydliga medicinska prioriteringar.
- Forskning
- Tisdag 23 februari 2016
Nytt samarbete ska ge bättre vård i Västsverige

Ett nytt avtal har tecknats om samarbete mellan akademisk forskning, hälso- och sjukvård och näringsliv. Den här gången är det företaget MSD som tillsammans med Sahlgrenska akademin och Västra Götalandsregionen ska driva projekt som syftar till bättre vård för patienter i Västsverige.
- Forskning
- Måndag 22 februari 2016
Forskare och patienter vill utrota hepatit C i Europa till år 2030

På ett möte i Bryssel den 17 februari presenterades ett manifest med budskapet att det är möjligt att göra Europa fritt från hepatit C till år 2030. Bakom manifestet står Hepatit B and C Public Policy Association, som samlar forskare, medicinska specialister och patientorganisationer.
- Forskning
- Fredag 19 februari 2016
Storsatsning på brittisk fond ger starkare band mellan företag och akademi

I Storbritannien skapas en ny fond för preklinisk forskning av tre globala läkemedelsföretag och tre universitet. Det är del av en trend med allt tätare samarbeten mellan industri och akademi, menar AstraZenecas science relations-ansvariga i Sverige.
- Forskning
- Onsdag 17 februari 2016
Innovationernas beskyddare är inte rädd för misstag

Sedan snart fyra år är Jennie Ekbeck VD för Umeå Biotech Incubator. I december utsågs hon till Årets innovationsängel 2015 av Vinnova och Veckans Affärer.– Jag tror att jag nominerades för att jag tänker nytt kring finansiering – och för att jag inte sitter med armarna i kors när jag tycker att något behöver förändras.
- Forskning
- Onsdag 10 februari 2016
Människans mikrober ska skärskådas i jakt på nya biomarkörer och läkemedel

Karolinska Institutet och läkemedelsföretaget Ferring ska tillsammans kartlägga mikroorganismerna som lever på och i människan, det så kallade mikrobiomet. Ett forskningscenter, finansierat av Ferring, ska etableras och en del av forskningen ska bedrivas vid forskningsinstitutet SciLifeLab.
- Forskning
- Måndag 1 februari 2016
Politisk allkonstnär ska lösa knutarna inom Life Science

Uppdraget till samordnaren Anders Lönnberg är lika kortfattat som svårt: Gör Sverige världsledande inom Life Science. Men om ännu en statlig utredning på ett antal hundra sidor vore det som krävdes hade nog Sveriges problem inom Life Science redan varit lösta. Därför har Anders Lönnberg valt en annan väg. Metoden är att få alla aktörer – verkligen alla – att inse att de själva måste bidra till förändring. Längs vägen har han kommit en ny sjukvårdsvision på spåren.
- Forskning
- Torsdag 28 januari 2016
AstraZeneca i Södertälje bygger för biologiska läkemedel – med hopp om expansion

För 2,5 miljarder kronor bygger AstraZeneca en ny fabrik för biologiska läkemedel utanför Södertälje. Det betyder ett par hundra nya tjänster, som bolaget räknar med att kunna fylla med Sverigerekryteringar. Men om koncernen utvidgar satsningen lär inte kompetensen i Sverige räcka till.
- Forskning
- Tisdag 26 januari 2016
Globala läkemedelsföretag i gemensam kamp mot resistenta bakterier
Över 80 globala läkemedelsföretag och en rad branschorganisationer publicerade på torsdagen, 21 januari, en deklaration om hur kampen mot resistenta bakterier kan förstärkas. Läkemedelsföretagen åtar sig att genomföra en rad åtgärder, och uppmanar regeringar världen över att samverka med företagen för att stoppa den negativa utvecklingen.
- Forskning
- Torsdag 21 januari 2016
Behandlingar mot cancer dominerar bland nya godkända läkemedel i Europa

Läkemedel mot cancer och blodsjukdomar dominerar fortfarande i listorna över nya godkända läkemedelssubstanser. Under 2015 rekommenderade den europeiska läkemedelsmyndigheten EMA att 39 nya läkemedelssubstanser skulle godkännas. 19 av dem utgör behandling av cancer och blodsjukdomar.
- Forskning
- Onsdag 20 januari 2016
Hot mot forskning undanröjda i kommande europeisk och svensk lagstiftning

Alla medlemsländer får likalydande lagregler om dataskydd från och med 2018 i enlighet med beslut i EU i december 2015. Skyddet för individers personliga integritet stärks samtidigt som registerforskning får stabila villkor. Nu kan det svenska arbetet med att skapa långsiktigt hållbara regler för framåtsyftande forskning som exempelvis Lifegene återupptas.
- Forskning
- Tisdag 12 januari 2016
Allt fler svenska företag utvecklar allt fler läkemedel
- Forskning
- Onsdag 30 december 2015
Svensk storsatsning på biologiska läkemedel
- Forskning
- Fredag 11 december 2015
Med nationell samordning kan mer läkemedelsforskning lockas till Sverige
- Forskning
- Onsdag 9 december 2015
Delade meningar om värdet av insamlade ostrukturerade data
- Forskning
- Onsdag 2 december 2015
Mer data från sjukvården behövs för att sänka dödlighet och öka patienters livskvalitet
- Forskning
- Tisdag 1 december 2015
Stor potential i Norden för forskning på data från den verkliga världen
- Forskning
- Torsdag 26 november 2015
OECD: Innovationspolitiken måste bättre möta de stora utmaningarna i samhället
- Forskning
- Onsdag 18 november 2015
Fördubbla anslagen till medicinsk forskning föreslår Forska!Sverige
- Forskning
- Fredag 13 november 2015
Snabbare godkännande av läkemedel utan rubbad risk/nytta-balans
- Forskning
- Onsdag 11 november 2015
Mätningar av innovationer i vården ska bli bättre och mer fördjupade
- Forskning
- Måndag 9 november 2015
Innovation i hela cancervårdkedjan kan ge fler patienter rätt vård i rätt tid
- Forskning
- Torsdag 5 november 2015
Vem ska ta den samordnande rollen kring läkemedels miljöpåverkan?
- Forskning
- Onsdag 4 november 2015
Ett starkare forskningssverige kan få global betydelse
- Forskning
- Torsdag 29 oktober 2015
Nu formas noderna i det nya ekosystemet för kliniska studier
- Forskning
- Onsdag 28 oktober 2015
Forskningsparken som ger grund för morgondagens exportintäkter
- Forskning
- Onsdag 21 oktober 2015
Ny infrastruktur ska se till att forskning blir en integrerad del av vården
- Forskning
- Tisdag 20 oktober 2015
Övergiven forskningsanläggning blev levande by
- Forskning
- Måndag 12 oktober 2015
Samarbete kring nytt instrument ger närbilder inifrån cellerna
- Forskning
- Fredag 9 oktober 2015
Smarta telefoner och appar erbjuder ny plattform för kliniska prövningar
- Forskning
- Torsdag 8 oktober 2015
Ny modell för statens riskkapital ska stimulera innovationer och företagande
- Forskning
- Torsdag 24 september 2015
För svensk framgång krävs uthålliga attraktiva villkor för unga forskare
- Forskning
- Tisdag 22 september 2015
EU och företagen förlänger samarbetet för att påskynda framtidens läkemedelsbehandlingar
- Forskning
- Måndag 21 september 2015
Innovativ ljusanvändning i Umeå från nytänkande landstingsråd
- Forskning
- Fredag 18 september 2015
ForskarFredag samlar forskare, allmänhet och skolelever för tionde året
- Forskning
- Tisdag 8 september 2015
Så här långt stor samsyn på behoven för svensk Life Science
- Forskning
- Tisdag 1 september 2015
Landets cancercentrum engagerar sig i uppbygget av en nationell forskningsportal
- Forskning
- Måndag 31 augusti 2015
Lite svårare att genomföra studier men fler läkemedel utprovas på barn trots allt
- Forskning
- Fredag 28 augusti 2015
”Biosimilarer” – kopiorna som inte är kopior
- Forskning
- Torsdag 27 augusti 2015